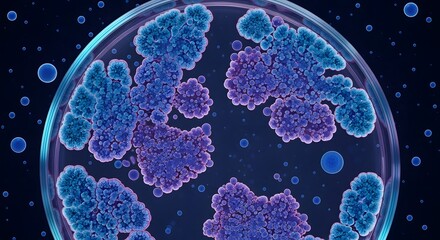
Petri Dish Close-Up with Growing Bacteria Colonies, Scientific Research

- Home >
- Stock Photos >
- Abstract DNA and Bacteria on Dark Scientific Background
Abstract DNA and Bacteria on Dark Scientific Background Image

This visual illustrates a blend of abstract DNA strands and bacteria floating against a dark background, a perfect representation for scientific use. Highlighting themes of genetics, microbiology, biology, and molecules, it could be used by educational publishers, research presentations, or in genetic studies content to visually communicate complex scientific topics effectively.
2
downloads
downloads
Tags:
More
Credit Photo
If you would like to credit the Photo, here are some ways you can do so
Text Link
photo Link
<span class="text-link">
<span>
<a target="_blank" href=https://pikwizard.com/photo/abstract-dna-and-bacteria-on-dark-scientific-background/cc63055e26a54e96c0b173a3b0f58dcf/>PikWizard</a>
</span>
</span>
<span class="image-link">
<span
style="margin: 0 0 20px 0; display: inline-block; vertical-align: middle; width: 100%;"
>
<a
target="_blank"
href="https://pikwizard.com/photo/abstract-dna-and-bacteria-on-dark-scientific-background/cc63055e26a54e96c0b173a3b0f58dcf/"
style="text-decoration: none; font-size: 10px; margin: 0;"
>
<img src="https://pikwizard.com/pw/medium/cc63055e26a54e96c0b173a3b0f58dcf.jpg" style="margin: 0; width: 100%;" alt="" />
<p style="font-size: 12px; margin: 0;">PikWizard</p>
</a>
</span>
</span>
Free (free of charge)
Free for personal and commercial use.
Author: People Creations
Similar Free Stock Images
Loading...